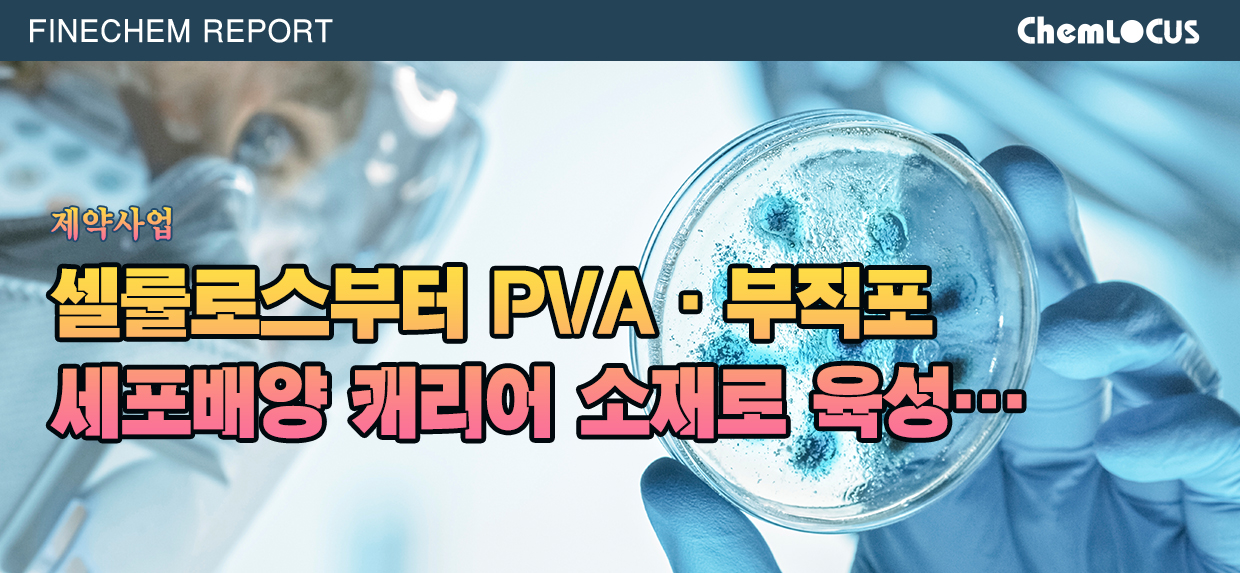

|
2025년 05월 19일
|
한줄의견
관련뉴스
| 제목 | 날짜 | 첨부 | 스크랩 |
|---|---|---|---|
| [제약] 제약산업, 계엄·내란 여파 “먹구름” | 2024-12-11 | ||
| [제약] 제약산업, 임상시험 지연 “심각” | 2020-05-19 | ||
| [제약] 제약산업, 코로나 부작용 심각하다! | 2020-04-28 | ||
| [제약] 제약산업, 브렉시트 충격 “제한적” | 2016-06-28 |
| 제목 | 날짜 | 첨부 | 스크랩 |
|---|---|---|---|
| [제약] 제약산업, 비만치료제 시장 급성장 | 2024-10-25 |